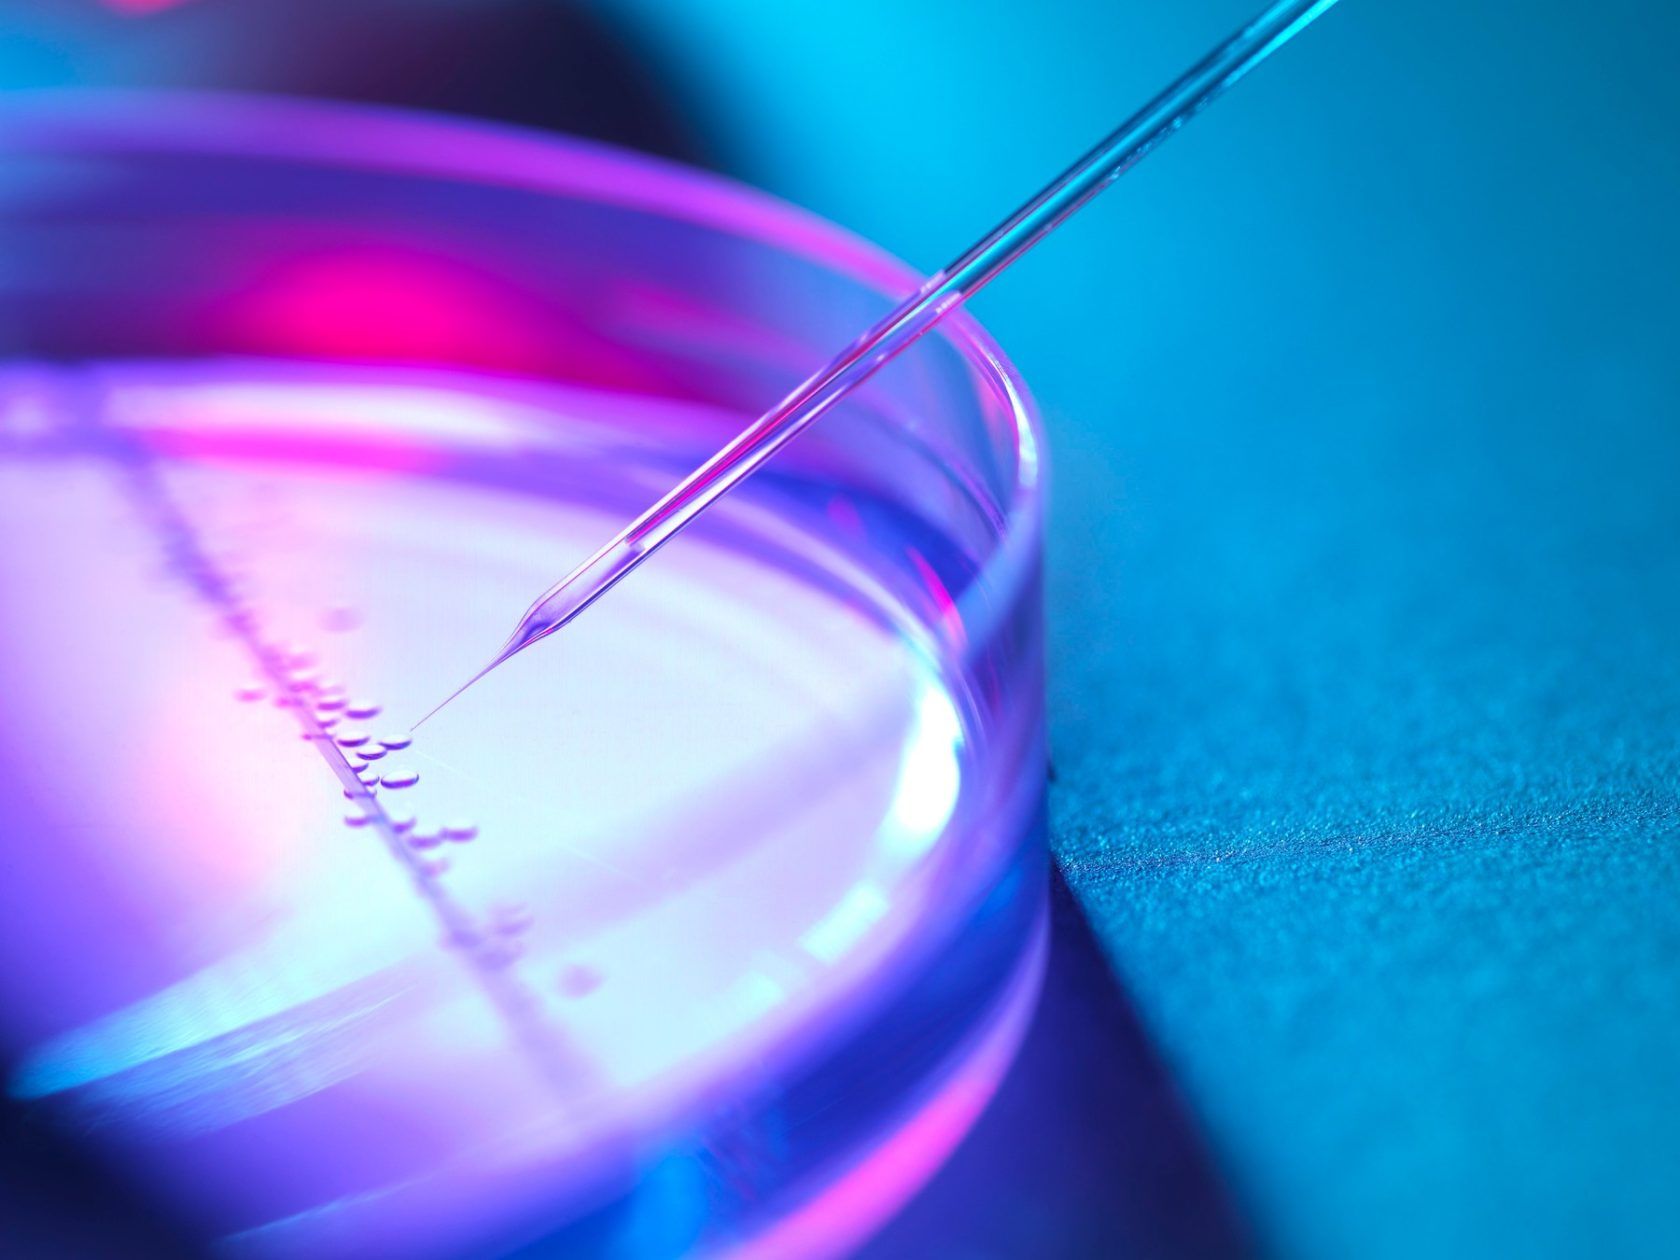

Saznali smo sve o prirodnom tretmanu koji zateže lice, briše mrlje i uklanja ožiljke
Posljednjih godina svjedočimo snažnom pomaku prema prirodnim tretmanima, osnaživanju vlastitih regenerativnih sposobnosti i iskorištavanju nevjerojatnog potencijala koji leži u našem tijelu.
Noviteti koji privlače pozornost
Spoj estetske medicine i njene „bliske rođakinje“ – regenerativne medicine, danas je jači no ikad, a noviteti iz ovog polja pojavljuju se gotovo svakodnevno.

Ipak, estetski liječnici smatraju kako neke metode još uvijek nisu dobile svu pozornost koju zaslužuju, a među njima najviše ističu korištenje matičnih stanica i krvne plazme u pomlađivanju i obnovi kože.
Ogroman potencijal krije se u našem tijelu
PRP i tretmani bazirani na produktima krvi i drugih stanica osobe već su godinama u ponudi brojnih poliklinika – no njihova najnovija generacija oduševljava čak i iskusne estetske liječnike. Temeljena na biološkom potencijalu pacijenta – jer se faktori rasta i matične stanice izoliraju upravo iz organizma osobe koju tretiramo – ova je metoda omogućila nevjerojatne učinke regeneracije, pomlađivanja i obnove tkiva i kože – i to bez unošenja ijedne strane tvari u organizam.
Kombiniranjem tretmana krvnom plazmom i matičnim stanicama, omogućeno je sinergijsko djelovanje – a potencijal je nevjerojatan. S obzirom na to da su estetska i regenerativna medicina relativno mlade grane, na novitete nailazimo svakodnevno, a najnovija generacija prirodnog pomlađivanja uključuje kombinaciju PRP-a (plazme bogate trombocitima i faktorima rasta) te tretmana matičnim stanicama iz vlastitog masnog tkiva pacijenta.
Tržišni lider donosi nam inovacije koje anti-ageing podižu na novu razinu
Za ove je inovativne metode zaslužna tvrtka Arthrex, jedan od najvećih globalnih proizvođača medicinskih uređaja te jedan od tržišnih lidera u području medicinske opreme. Inovacije, patenti i posebno osmišljene procedure za koje je zaslužna ova tvrtka oduševili su liječnike diljem svijeta i pomogle stotinama tisuća ljudi u dobivanju medicinsko-estetskih usluga najviše kvalitete.
Kako izgleda najnoviji tretman – koji kombinira PRP i matične stanice dobivene iz masnog tkiva? O čemu je točno riječ, koje se regije mogu tretirati te kakve rezultate očekivati – doznali smo od liječničkog tima Poliklinike Kvaternik.

Što su nam otkrili dr. Irena Pirkl Lončar, spec. otorinolaringologije i subspec. plastične i rekonstrukcijske kirurgije glave vrata te dr. Marko Barić, spec. opće kirurgije i subspec. plastične i rekonstrukcijske kirurgije?
Dr. Irena Pirkl Lončar, specijalist otorinolaringologije Subspecijalist plastične i rekonstrukcijske kirurgije glave i vrata
Dr. Marko Barić, specijalist opće kirurgije Subspecijalist plastične i rekonstrukcijske kirurgije
Navikli smo o PRP tretmanu i matičnim stanicama slušati u kontekstu regenerativne medicine. Iako klasični PRP koristi trombocite izdvojene iz krvi pacijenta, u ovom tretmanu koriste se matične stanice izdvojene iz masti. Imaju li ove matične stanice jaču sposobnost regeneracije od faktora rasta koje izdvajamo iz trombocita?
Matične stanice dobivene iz masti, prvi put otkrivene 2001. god., su nespecijalizirane, nediferencirane, nezrele, multipotentne stanice mezenhimalnog podrijetla koje imaju proliferacijski potencijal i sposobnost diferenciranja te se uz pomoć određenih signala mogu razviti u razne vrsta stanica i tkiva u čijem miljeu se nađu te tako zamijeniti istrošena ili oštećena tkiva. Za razliku od PRP-a gdje se aktivna tvar dobiva iz krvi, matične stanice se dobivaju iz vlastitog masnog tkiva i taj produkt se naziva nanofat.
Koncentracija matičnih stanica dobivenih iz masti je veća nego kod klasičnog PRP-a pa je time i efekt nakon aplikacije jači. Nanofat se dobiva mehaničkom emulzifikacijom i procesom filtracije, prilikom čega se unište adipociti te ostanu matične stanice – a njihov glavni učinak je poboljšanje elastičnosti kože zbog pojačane sinteze i remodeliranja kolagena i elastina na mjestu aplikacije. Glavna klinička aplikacija je stimulacija regeneracije tkiva, poboljšanje kvalitete kože i uklanjanje diskoloracija.
Prije i poslije, iz arhive tvrtke Arthrex
Najnovija generacija uređaja uvelike je unaprijedila svijet estetske i regenerativne medicine. Možete li nam reći nešto o novim sustavima, poput Arthrexovog, s kojim su mogućnosti prirodnog pomlađivanja zaista podignute na novu razinu?
Uređaji poput Arthrexovog liječniku olakšavaju proces procesiranja masti u matične stanice, odnosno emulzifikaciju i filtraciju, to se više ne mora raditi ručno i samim time je postupak jednostavniji.

Možete li nam objasniti glavne benefite matičnih stanica i njihovu sposobnost regeneracije oštećenih stanica? Zašto su nam toliko korisne u regenerativnoj, ali i estetskoj medicini – u čemu pokazuju najbolje rezultate?
Matične stanice dobivene iz masti tj. nanofat prvenstveno se koristi za regeneraciju i poboljšanje kvalitete tkiva. Mogu se koristiti za obnovu kože i popravljanje njene kvalitete (zatezanje kože vraćanjem elastičnosti), zatim za tretiranje ožiljaka od akni ili opekotina, za tretiranje oštećenja kože poput strija te posljedica izlaganja suncu, a izvrsne rezultate pokazuje i kod tretiranja pigmentacija poput tamnih podočnjaka te tretiranje alopecije.

Ovakav tip tretmana zapravo podrazumijeva tri zahvata u jednom – lipotransfer, tretman matičnim stanicama i PRP. Time se postiže dvostruki učinak – regeneracija stanica i nadoknada volumena na dijelovima lica koja su s vremenom izgubila na volumenu i zategnutosti. Kome je namijenjen ovakav tip tretmana? Tko će od njega imati najviše koristi?
Ovakav zahvat je namijenjen osobama umjereno smanjenog volumena lica, osobama s izraženim borama i/ili ožiljcima kod kojih će efekt biti značajan. S jedne strane lipofillingom (microfat graftingom) se nadoknađuje volumen lica, dok se s druge strane aplikacijom matičnih stanica (nanofat grafting) i PRP-om poboljšava kvaliteta kože.
Prije i poslije, iz arhive tvrtke Arthrex
Može li ovakav tip tretmana zamijeniti hijaluronske filere? Koje su prednosti, a koji nedostaci?
Lipofilling je tehnika pri kojoj se masno tkivo uzima s dijelova tijela gdje ga ima viška i aplicira se tamo gdje je potrebno nadoknaditi volumen. Sličnost s filerima je ta da obje tehnike nadoknađuju volumen lica i smanjuju bore, no tretmani imaju i svoje razlike.
Neke od prednosti lipofilinga u odnosu na dermalne filere uključuju korištenje prirodnog materijala za nadoknadu volumena (vlastite masnoće) – čime se smanjuje mogućnost alergijske reakcije, kao i činjenica da je rezultat lipofilinga dugotrajan te se ne mora ponavljati – zbog čega su dugoročni troškovi održavanja volumena manji u odnosu na filere. Osim toga, ovaj tretman ne radi samo nadoknadu volumena, već i osigurava revitalizaciju kože i mladenački izgled – zahvaljujući matičnim stanicama. Ipak, valja imati na umu kako lipotransfer zahtijeva nešto duži oporavak nego fileri (nekoliko dana), a i kratkoročna cijena zahvata veća je nego cijena aplikacije filera. No – imamo li na umu da je riječ o pomlađivanju cijelog lica, ove tretmane ne bismo trebali uspoređivati po kriteriju cijene.
Djeluje li poput faceliftinga, koliko može zategnuti opuštenu kožu lica?
Lipofilling tj. transfer masti kao nadoknada volumena može djelomično podignuti opuštene dijelove lica, no ne može u potpunosti zamijeniti kirurške operacijske metode facelifta.

Djeluje li na volumen na konkretnim dijelovima lica, primjerice na obrazima?
Ovisno u kojoj regiji nedostaje volumena, ta regija se tretira – mast se aplicira u masne odjeljke lica koji imaju najveći manjak. Duboki masni odjeljci na licu se tretiraju prvi. Injekcije uvijek počinju duboko, tretira se nazolabijalni i duboki malarni odjeljak, nakon čega slijede površinski gornji i donji malarni odjeljci.
Može li ovaj tretman napraviti osoba koja je do sada radila tretmane filerima, postoje li nekakve prepreke?
Ne postoji prepreka u tretmanu lipofillinga lica i tretmana matičnim stanicama kod osoba kod kojih su ranije aplicirani fileri. Naime, s obzirom na to da se radi o vlastitom tkivu (vlastitoj masti), nema imunološke reakcije odbacivanja ili alergijske reakcije.

Jesu li rezultati vidljivi odmah ili je na njih potrebno pričekati?
Ukoliko se radi o nadoknadi volumena (microfat grafting tj. lipofilling), rezultati su vidljivi odmah po splašnjavanju oteklina, dok se kod tretmana matičnim stanicama (nanofat grafting i PRP) efekt poboljšanja kvalitete kože vidi nakon 3-6 mjeseci.
Koliko traju rezultati, treba li se postupak ponavljati?
Kao i kod svake transplantacije masti, računa se da će se oko 30% masnih stanica apsorbirati tj. neće se „primiti“ – a taj postotak kod pušača može biti i veći, zbog čega se savjetuje apstinencija od pušenja minimalno 30 dana prije operacijskog zahvata. Rezultati traju doživotno, no potrebno je imati na umu da je daljnjim starenjem i mijenjanjem tjelesne težine (mršavljenjem), zahvaćeno i transplantirano masno tkivo te dolazi do redukcije istog. Značajna karakteristika je dugoročni učinak nanofata (matičnih stanica) za razliku od drugih tretmana kože koji zahtijevaju više tretmana.
Je li postupak bolan, iz kojeg dijela tijela se uzimaju masne stanice?
Postupak se izvodi u lokalnoj tumescentnoj anesteziji, a mast se uzima najčešće iz donjeg dijela trbušne stijenke, unutarnje strane bedara, no može se uzeti i sa drugih dijelova tijela gdje postoji „višak“ masti.

Koja je okvirna cijena tretmana?
Cijena ovisi o količini apliciranih matičnih stanica, odnosno o veličini tretiranog područja. Raspon cijena je otprilike od 5.000 do 10.000 kn. Ako se matične stanice apliciraju u zglobove, onda je cijena viša, oko 15.000 kn.
Postoji li mogućnost nekih nepovoljnih reakcija?
Nakon aplikacije nanofata nastaje žućkasta diskoloracija kože koja obično nestaje nekoliko sati nakon injiciranja. Klinički rezultati postepeno se poboljšavaju s vremenom te su vidljivi nakon otprilike 3 – 6 mjeseci. Privremeno crvenilo u injiciranom području traje 1,5 – 2 dana, a u slučajevima tretiranja tamnih dijelova kože pozitivnom učinku prethodi duža faza crvenila, koja nastaje zbog preraspodjele mekog tkiva.

Kao moguća komplikacija lipofillinga mogu nastati infekcije, granulomi, masne ciste ili pretjerana korekcija s masti koju je kasnije teško ispraviti. Dakle, bolje je hipokorigirati pa eventualno kasnije napraviti „touch up“ ako se pokaže potreba nego hiperkorigirati.